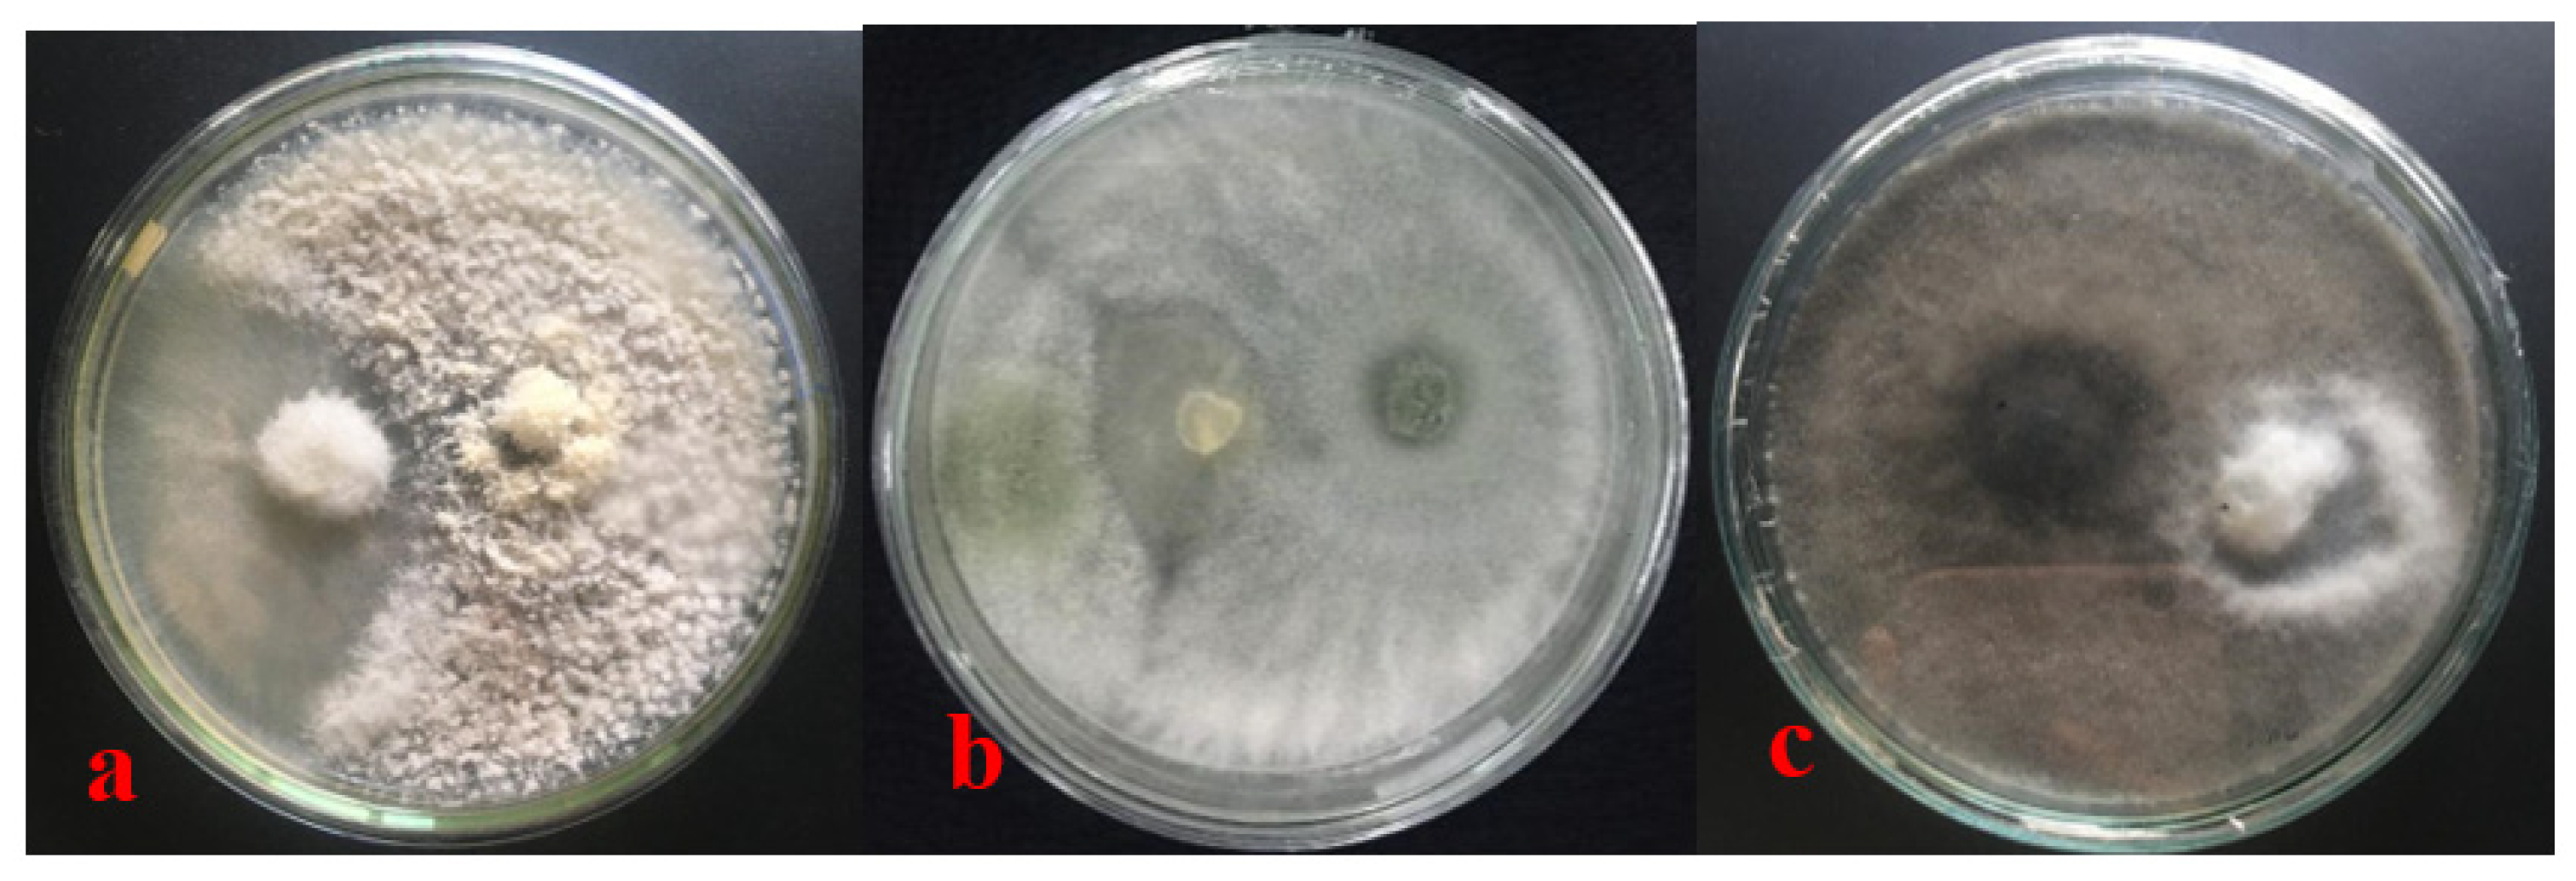
Forests 14 00167 g005 Forests 14 00167 g005

Potential of Phylloplane Fungi from Mangrove Plant (Rhizophora apiculata Blume) as Biological Control Agents against Fusarium oxysporum f. sp. cubense in Banana Plant (Musa acuminata L.)
Abstract
1. Introduction
2. Materials and Methods
2.1. Sampling
2.2. Isolation of Phylloplane Fungal and Pathogenic Fungi
2.3. Postulate Koch Test
2.4. DNA-Based Identification
2.5. In Vitro Assays Antagonist Test
2.6. Greenhouse Test of Phylloplane Fungal vs. Foc
2.7. Data Analysis
3. Results
3.1. Fungal Phylloplane from Mangrove
3.2. Postulate Koch Test
3.3. Antagonism of Fungal Phylloplanes against Foc
3.3.1. In Vitro Assays
3.3.2. Greenhouse Test of Fungal Phylloplanes vs. Foc
4. Discussion
4.1. Fungal Phylloplanes from Mangroves
4.2. Antagonism of Fungal Phylloplanes against Foc
4.2.1. In Vitro Assay
4.2.2. Greenhouse Test of Fungal Phylloplanes vs. Foc
5. Conclusions
Author Contributions
Funding
Data Availability Statement
Acknowledgments
Conflicts of Interest
References
- Anandhu, R. Studies on Phylloplane and Endophytic Fungi Isolated from Mangrove Plants and Their Bioactive Compounds. Ph.D. Thesis, Department of Botany, KMCPGS, Pondicherry University, Puducherry, India, 2016. [Google Scholar]
- Patra, J.K.; Mohanta, Y.K. Antimicrobial compounds from mangrove plants: A pharmaceutical prospective. Chin. J. Integr. Med. 2014, 20, 311–320. [Google Scholar] [CrossRef]
- Bose, S.; Bose, A. Antimicrobial activity of Acanthus ilicifolius (L.). Indian J. Pharm. Sci. 2008, 70, 821–823. [Google Scholar] [CrossRef]
- Goswami, S.; Goel, N.; Majumdar, R.S. Phylloplane microbes impact host physiology: A review. J. Plant Prot. Res. 2021, 61, 213–221. [Google Scholar] [CrossRef]
- Thakur, S.; Harsh, N.S.K. Phylloplane fungi as biocontrol agent against Alternaria leaf spot disease of (Akarkara) Spilanthes oleracea. Biosci. Discov. 2014, 5, 139–144. [Google Scholar]
- Chauhan, R.; Navneet; Gautam, S.S. Potential antagonistic phylloplane fungi from Stevia rebaudiana Bert. as bio-control of aerial blight disease caused by Rhizoctonia solani. Indian Phytopathol. 2019, 72, 177–180. [Google Scholar] [CrossRef]
- Hamzah, T.N.T.; Lee, S.Y.; Hidayat, A.; Terhem, R.; Faridah-Hanum, I.; Mohamed, R. Diversity and Characterization of Endophytic Fungi Isolated From the Tropical Mangrove Species, Rhizophora mucronata, and Identification of Potential Antagonists Against the Soil-Borne Fungus, Fusarium solani. Front. Microbiol. 2018, 9, 1707. [Google Scholar] [CrossRef] [PubMed]
- Nayak, B.K.; Anandhu, R. Biodiversity of phylloplane and endophytic fungi from different aged leaves of medicinal mangrove plant species. Avicennia Mar. J. Pharm. Sci. Res. 2017, 9, 6–9. [Google Scholar]
- Dita, M.; Barquero, M.; Heck, D.W.; Mizubuti, E.S.G.; Staver, C.P. Fusarium Wilt of Banana: Current Knowledge on Epidemiology and Research Needs Toward Sustainable Disease Management. Front. Plant Sci. 2018, 871, 1468. [Google Scholar] [CrossRef]
- Abo-Elyousr, K.A.M.; Abdel-Hafez, S.I.I.; Abdel-Rahim, I.R. Isolation of Trichoderma and Evaluation of their Antagonistic Potential against Alternaria porri. J. Phytopathol. 2014, 162, 567–574. [Google Scholar] [CrossRef]
- Wibowo, A.; Subandiyah, S.; Sumardiyono, C.; Sulistyowati, L.; Taylor, P.; Fegan, M. Occurrence of Tropical Race 4 of Fusarium oxysporum f. sp. cubense in Indonesia. Plant Pathol. J. 2011, 27, 280–284. [Google Scholar] [CrossRef]
- Sari, W.; Rosmeita, C.N. Identifikasi molekuler cendawan entomopatogen Beauveria Bassiana dan Metarhizium anisopliae asal isolat Cianjur. Pro-STek 2020, 1, 1–9. [Google Scholar] [CrossRef]
- White, T.J.; Bruns, T.; Lee, S.; Taylor, J.W. Amplification and direct sequencing of fungal ribosomal RNA genes for phylogenetics. In PCR Proto-Cols: A Guide to Methods and Applications; Innis, M., Gelfand, D., Sninsky, J., White, T., Eds.; Academic Press Inc.: New York, NY, USA, 1990; Volume 64, pp. 315–322. [Google Scholar]
- Hartanto, E.S.; Heni, K. Uji antagonis 5 isolat trichoderma dari rizosfer pinus sp terhadap pertumbuhan cendawan colletotricum sp penyebab penyakit antraknos pada cabai secara in vitro. In Prosiding Symbion (Symposium Biology Education. Program Study Biology Education. FKIP; Ahmad Dahlan University: Yogyakarta, Indonesia, 2016; pp. 205–212. [Google Scholar]
- Wheeler, K.A.; Hocking, A.D. Interactions among xerophilic fungi associated with dried salted fish. J. Appl. Bacteriol. 1993, 74, 164–169. [Google Scholar] [CrossRef] [PubMed]
- Emilda, D.; Sutanto, A.; Sukartini; Jumjunidang. Application of salicylic acid to induce disease resistance against fusarium wilt on banana. IOP Conf. Ser. Earth Environ. Sci. 2020, 468, 012026. [Google Scholar] [CrossRef]
- Catambacan, D.; Cumagun, C. Weed-Associated Fungal Endophytes as Biocontrol Agents of Fusarium oxysporum f. sp. cubense TR4 in Cavendish Banana. J. Fungi 2021, 7, 224. [Google Scholar] [CrossRef]
- Lee, O.H.K.; Hyde, K.D. Phylloplane fungi in Hong Kong mangroves: Evaluation of study methods. Mycologia 2002, 94, 596–606. [Google Scholar] [CrossRef]
- Legiastuti, T.S.; Aminingsih, T. Identifikasi Cendawan Endofit Menggunakan Teknik Polymerase Chain Reaction. J. Fitopatol. Indones. 2012, 8, 31–36. [Google Scholar] [CrossRef]
- Lutzoni, F.; Kauff, F.; Cox, C.J.; McLaughlin, D.; Celio, G.; Dentinger, B.; Padamsee, M.; Hibbett, D.; James, T.Y.; Baloch, E.; et al. Assembling the fungal tree of life: Progress, classification, and evolution of subcellular traits. Am. J. Bot. 2004, 91, 1446–1480. [Google Scholar] [CrossRef]
- Schoch, C.L.; Sung, G.-H.; López-Giráldez, F.; Townsend, J.P.; Miadlikowska, J.; Hofstetter, V.; Robbertse, B.; Matheny, P.B.; Kauff, F.; Wang, Z.; et al. The Ascomycota Tree of Life: A Phylum-wide Phylogeny Clarifies the Origin and Evolution of Fundamental Reproductive and Ecological Traits. Syst. Biol. 2009, 58, 224–239. [Google Scholar] [CrossRef]
- Naranjo-Ortiz, M.Á.; Gabaldón, T. Fungal evolution: Diversity, taxonomy and phylogeny of the Fungi. Biol. Rev. 2019, 58, 224–239. [Google Scholar] [CrossRef]
- Naikwade, P.; Mogle, U.; Sankpal, S. Phyloplane mycoflora associated with Mangrove plant Ceriops tagal (Perr.). 2012. Available online: https://jsrr.net/Vol%202%20No.%201/Naikwade85-87.pdf (accessed on 28 October 2022).
- Thambugala, K.M.; Daranagama, D.A.; Phillips, A.J.L.; Kannangara, S.D.; Promputtha, I. Fungi vs. Fungi in Biocontrol: An Overview of Fungal Antagonists Applied Against Fungal Plant Pathogens. Front. Cell. Infect. Microbiol. 2020, 10, 604923. [Google Scholar] [CrossRef]
- Nayak, D.; Mishra, M.; Pradhan, B.; Sharma, K.K. Evaluation of some bio-control agents in in vitro control of Fusarium oxysporum f. sp. cubense, an incitant of banana panama wilt. J. Pharmacogn. Phytochem. 2020, 9, 751–753. [Google Scholar]
- Napitupulu, T.P. In vitro evaluation of Trichoderma harzianum strains for the control of Fusarium oxysporum f. sp. cubense. Plant Pathol. Quar. 2019, 9, 152–159. [Google Scholar] [CrossRef]
- Mmbaga, T.; Gurung, S.; Maheshwari, A. Screening of Plant Endophytes as Biological Control Agents against Root Rot Pathogens of Pepper (Capsicum annum L.). J. Plant Pathol. Microbiol. 2018, 9, 3. [Google Scholar] [CrossRef]
- Kim, J.C.; Choi, G.J.; Park, J.H.; Kim, H.T.; Cho, K.Y. Activity against plant pathogenic fungi of phomalactone isolated from Nigrospora sphaerica. Pest Manag. Sci. 2001, 57, 554–559. [Google Scholar] [CrossRef] [PubMed]
- Salvatore, M.M.; Alves, A.; Andolfi, A. Secondary Metabolites of Lasiodiplodia theobromae: Distribution, Chemical Diversity, Bioactivity, and Implications of Their Occurrence. Toxins 2020, 12, 457. [Google Scholar] [CrossRef]
- Zhou, J.; Diao, X.; Wang, T.; Chen, G.; Lin, Q.; Yang, X.; Xu, J. Phylogenetic diversity and antioxidant activities of culturable fungal endophytes associated with the mangrove species Rhizophora stylosa and R. mucronata in the South China Sea. PLoS ONE 2018, 13, e0197359. [Google Scholar] [CrossRef]
- Eng, F.; Haroth, S.; Feussner, K.; Meldau, D.; Rekhter, D.; Ischebeck, T.; Brodhun, F.; Feussner, I. Optimized Jasmonic Acid Production by Lasiodiplodia theobromae Reveals Formation of Valuable Plant Secondary Metabolites. PLoS ONE 2016, 11, e0167627. [Google Scholar] [CrossRef]
- Wasternack, C.; Hause, B. Jasmonates: Biosynthesis, perception, signal transduction and action in plant stress response, growth and development. An update to the 2007 review in Annals of Botany. Ann. Bot. 2013, 111, 1021–1058. [Google Scholar] [CrossRef]
- Zhao, J.H.; Zhang, Y.L.; Wang, L.W.; Wang, J.Y. Bioactive secondary metabolites from Nigrospora sp. LLGLM003, an endophytic fungus of the medicinal plant Moringa oleifera Lam. World J. Microbiol. Biotechnol. 2012, 28, 2107–2112. [Google Scholar] [CrossRef]
- Al-Ani, L.K.T. Trichoderma: Beneficial Role in Sustainable Agriculture by Plant Disease Management. In Plant Microbiome: Stress Response; Springer: Berlin/Heidelberg, Germany, 2018; pp. 105–126. [Google Scholar] [CrossRef]
- Al-ani, L.K.T.; Albaayit, S.F.A. Antagonistic of some Trichoderma against Fusarium oxysporum sp. f. cubense tropical race 4 (FocTR4). Eurasia Proc. Sci. Technol. Eng. Math. 2018, 2, 35–38. [Google Scholar]
- Sudantha, I.M. Characterization and virulence of Fusarium oxysporum f. sp. cubense cause wilt disease in banana plants and its biological control using endophytic fungi Trichoderma spp. At West Nusa Tenggara, Indonesia. IOP Conf. Ser. Earth Environ. Sci. 2021, 886, 1. [Google Scholar] [CrossRef]
- Ghag, S.B.; Shekhawat, U.K.; Ganapathi, T.R. Fusarium wilt of banana: Biology, epidemiology and management. Int. J. Pest Manag. 2015, 61, 250–263. [Google Scholar] [CrossRef]
- Li, C.; Chen, S.; Zuo, C.; Sun, Q.; Ye, Q.; Yi, G.; Huang, B. The use of GFP-transformed isolates to study infection of banana with Fusarium oxysporum f. sp. cubense race 4. Eur. J. Plant Pathol. 2011, 131, 327–340. [Google Scholar] [CrossRef]
- Yadeta, K.A.; Thomma, B.P.H.J. The xylem as battleground for plant hosts and vascular wilt pathogens. Front. Plant Sci. 2013, 4, 1–12. [Google Scholar] [CrossRef] [PubMed]
- Yoshida, S. Molecular regulation of leaf senescence. Curr. Opin. Plant Biol. 2003, 6, 79–84. [Google Scholar] [CrossRef] [PubMed]
- Dong, X.; Xiong, Y.; Ling, N.; Shen, Q.; Guo, S. Fusaric acid accelerates the senescence of leaf in banana when infected by Fusarium. World J. Microbiol. Biotechnol. 2014, 30, 1399–1408. [Google Scholar] [CrossRef]
- Pyung, O.L.; Hyo, J.K.; Hong, G.N. Leaf senescence. Annu. Rev. Plant Biol. 2007, 58, 115–136. [Google Scholar] [CrossRef]
- Préstamo, G.; Manzano, P. Peroxidases of Selected Fruits and Vegetables and the Possible Use of Ascorbic Acid as an Antioxidant. Hortscience 2019, 28, 48–50. [Google Scholar] [CrossRef]
- Czymmek, K.J.; Fogg, M.; Powell, D.H.; Sweigard, J.; Park, S.-Y.; Kang, S. In vivo time-lapse documentation using confocal and multi-photon microscopy reveals the mechanisms of invasion into the Arabidopsis root vascular system by Fusarium oxysporum. Fungal Genet. Biol. 2007, 44, 1011–1023. [Google Scholar] [CrossRef]
- Bacon, C.W.; Porter, J.K.; Norred, W.P.; Leslie, J.F. Production of fusaric acid by Fusarium species. Appl. Environ. Microbiol. 1996, 62, 4039–4043. [Google Scholar] [CrossRef]
- Gapillout, I.; Milat, M.-L.; Blein, J.-P. Effects of fusaric acid on cells from tomato cultivars resistant or susceptible to Fusarium oxysporum f. sp.Lycopersici. Eur. J. Plant Pathol. 1996, 102, 127–132. [Google Scholar] [CrossRef]
- Rahayu, G.; Maulana, I. Widodo Endobacterial symbiont of Fusarium oxysporum f. sp. cubense and the pathogenicity of their symbiosis towards banana plantling. IOP Conf. Ser. Earth Environ. Sci. 2020, 457, 012051. [Google Scholar] [CrossRef]
- Chen, Z.; Luo, Q.; Wang, M.; Chen, B. A Rapid Method with UPLC for the Determination of Fusaric Acid in Fusarium Strains and Commercial Food and Feed Products. Indian J. Microbiol. 2017, 57, 68–74. [Google Scholar] [CrossRef] [PubMed]
- Dong, X.; Ling, N.; Wang, M.; Shen, Q.; Guo, S. Fusaric acid is a crucial factor in the disturbance of leaf water imbalance in Fusarium-infected banana plants. Plant Physiol. Biochem. 2012, 60, 171–179. [Google Scholar] [CrossRef] [PubMed]
- Basyuni, M.; Baba, S.; Kinjo, Y.; Oku, H. Salinity increases the triterpenoid content of a salt secretor and a non-salt secretor mangrove. Aquat. Bot. 2012, 97, 17–23. [Google Scholar] [CrossRef]
- Inafuku, M.; Basyuni, M.; Oku, H. Triterpenoid modulates the salt tolerance of lanosterol synthase deficient Saccharomyces cerevisiae, GIL77. Saudi J. Biol. Sci. 2018, 25, 1–9. [Google Scholar] [CrossRef] [PubMed]
- Shaukat, S.S.; Zafar, H.; Ahmed, W.; Khan, M.; Zaidi, S. Diversity of Phylloplane Mycobiota of Avicennia Marina (Forssk.) Vierh. and Rhizophora Mucronata Poir. At Indus Delta, Sindh Coast, Pakistan. Int. J. Biol. Biotech 2013, 10, 45–51. [Google Scholar]
- Bubici, G.; Kaushal, M.; Prigigallo, M.I.; Cabanás, C.G.-L.; Mercado-Blanco, J. Biological Control Agents Against Fusarium Wilt of Banana. Front. Microbiol. 2019, 10, 616. [Google Scholar] [CrossRef]
- Suárez-Estrella, F.; Arcos-Nievas, M.; López, M.; Vargas-García, M.; Moreno, J. Biological control of plant pathogens by microorganisms isolated from agro-industrial composts. Biol. Control 2013, 67, 509–515. [Google Scholar] [CrossRef]
- Yan, J.; Broughton, S.; Yang, S.; Gange, A. Do endophytic fungi grow through their hosts systemically? Fungal Ecol. 2015, 13, 53–59. [Google Scholar] [CrossRef]
- Busby, P.E.; Ridout, M.; Newcombe, G. Fungal endophytes: Modifiers of plant disease. Plant Mol. Biol. 2016, 90, 645–655. [Google Scholar] [CrossRef] [PubMed]
- Lecomte, C.; Alabouvette, C.; Edel-Hermann, V.; Robert, F.; Steinberg, C. Biological control of ornamental plant diseases caused by Fusarium oxysporum: A review. Biol. Control 2016, 101, 17–30. [Google Scholar] [CrossRef]
- Cheong, S.L.; Cheow, Y.L.; Ting, A.S.Y. Characterizing antagonistic activities and host compatibility (via simple endophyte-calli test) of endophytes as biocontrol agents of Ganoderma boninense. Biol. Control 2017, 105, 86–92. [Google Scholar] [CrossRef]
- De Silva, N.I.; Brooks, S.; Lumyong, S.; Hyde, K.D. Use of endophytes as biocontrol agents. Fungal Biol. Rev. 2019, 33, 133–148. [Google Scholar] [CrossRef]
- Innerebner, G.; Knief, C.; Vorholt, J.A. Protection of Arabidopsis thaliana against Leaf-Pathogenic Pseudomonas syringae by Sphingomonas Strains in a Controlled Model System. Appl. Environ. Microbiol. 2011, 77, 3202–3210. [Google Scholar] [CrossRef]
- Ritpitakphong, U.; Falquet, L.; Vimoltust, A.; Berger, A.; Métraux, J.; L’Haridon, F. The microbiome of the leaf surface of Arabidopsis protects against a fungal pathogen. New Phytol. 2016, 210, 1033–1043. [Google Scholar] [CrossRef] [PubMed]
- Mazinani, Z.; Zamani, M.; Sardari, S. Isolation and identification of phyllospheric bacteria possessing antimicrobial activity from Astragalus obtusifolius, Prosopis juliflora, Xanthium strumarium and Hippocrepis unisiliqousa. Avicenna J. Med. Biotechnol. 2017, 9, 31–37. [Google Scholar] [PubMed]
- Lindow, S.E.; Brandl, M.T. Microbiology of the Phyllosphere. Appl. Environ. Microbiol. 2003, 69, 1875–1883. [Google Scholar] [CrossRef] [PubMed]

| Percentage of Disease % | Severity Index | ||
|---|---|---|---|
| Leaf | Rhizome | Resistance Category | |
| 0 | 1 | 1 | Very resistant |
| 20 | 1–2 | 1–2 | Resistant |
| 20–50 | 2–3 | 2–3 | Moderate resistance |
| 50–75 | 3–4 | 3–5 | Susceptible |
| >75 | >4 | >5 | Very susceptible |
| Fungus | Percentage of Inhibition (%) |
|---|---|
| Lasiodiplodia theobromae | 67.43 c ± 2.66 |
| Trichoderma harzianum strain QTYC64 | 66.65 bc ± 14.352 |
| Nigrospora sphaerica | 65.33 bc ± 3.850 |
| Fusarium incarnatum | 48.95 abc ± 1.391 |
| Curvularia clavata | 48.83 abc ± 17.806 |
| Nigrospora sp. | 48.54 abc ± 8.174 |
| Pestalotiopsis microspora | 47.33 abc ± 3.055 |
| Nigrospora sp. | 44.09 abc ± 2.297 |
| Pestalotiopsis sp. | 43.78 abc ± 10.633 |
| Nigrospora singularis | 43.36 abc ± 8.474 |
| Penicillium oxalicum | 43.30 abc ± 13.702 |
| Trichoderma harzianum strain WJF52 | 42.00 abc ± 4.163 |
| Aspergillus versicolor | 38.94 abc ± 6.075 |
| Fusarium solani | 37.44 ab ± 13.722 |
| Fusarium oxysporum | 35.34 a ± 12.055 |
| A5 (Not significant similarity found) | 29.78 a ± 0.773 |
| A8 (Not significant similarity found) | 26.28 a ± 14.144 |
| Myrothecium sp. | 25.19 a ± 2.468 |
| Neopestalotiopsis clavispora | 24.17 a ± 13.687 |
| Scopulariopsis brevicaulis | 20.00 a ± 5.814 |
| Treatment | Weeks | |||||||
|---|---|---|---|---|---|---|---|---|
| 1 | 2 | 3 | 4 | 5 | 6 | 7 | 8 | |
| K+ | 2.77 a | 5.55 a | 16.66 a | 16.66 a | 22.22 b | 52.77 b | 100.00 a | 100.00 b |
| K− | 0.00 a | 0.00 a | 5.55 a | 0.00 a | 0.00 a | 8.33 a | 22.22 a | 69.43 a |
| Trichoderma harzianum | 0.00 a | 0.00 a | 5.55 a | 8.33 a | 0.00 a | 11.11 a | 25.55 a | 63.88 a |
| Nigrospora sphaerica | 0.00 a | 0.00 a | 5.55 a | 16.66 a | 2.77 a | 11.11 a | 33.33 a | 69.44 a |
| Lasiodiplodia theobromae | 0.00 a | 0.00 a | 2.77 a | 8.33 a | 2.77 a | 5.55 a | 20.81 a | 80.55 a |
| Treatment | Weeks | |||||||
|---|---|---|---|---|---|---|---|---|
| 1 | 2 | 3 | 4 | 5 | 6 | 7 | 8 | |
| K+ | 0.69 a | 1.38 a | 4.16 a | 6.24 a | 7.63 b | 21.52 b | 40.27 b | 48.60 b |
| K− | 0.00 a | 0.00 a | 2.08 a | 0.00 a | 0.00 a | 2.08 a | 5.55 a | 18.67 a |
| Trichoderma harzianum | 0.00 a | 0.00 a | 1.38 a | 2.08 a | 0.00 a | 2.77 a | 7.63 a | 16.66 a |
| Nigrospora sphaerica | 0.00 a | 0.00 a | 1.38 a | 4.16 a | 0.69 a | 2.77 a | 9.72 a | 24.30 a |
| Lasiodiplodia theobromae | 0.00 a | 0.00 a | 0.69 a | 2.08 a | 1.38 a | 2.08 a | 7.63 a | 25.69 a |
| Treatment | Incidence | Severity |
|---|---|---|
| K+ | 77.77 c | 26.10 b |
| K− | 0.00 a | 0.00 a |
| Trichoderma harzianum | 30.55 b | 6.80 a |
| Nigrospora sphaerica | 16.66 ab | 2.77 a |
| Lasiodiplodia theobromae | 11.11 ab | 3.88 a |
Disclaimer/Publisher’s Note: The statements, opinions and data contained in all publications are solely those of the individual author(s) and contributor(s) and not of MDPI and/or the editor(s). MDPI and/or the editor(s) disclaim responsibility for any injury to people or property resulting from any ideas, methods, instructions or products referred to in the content. |
© 2023 by the authors. Licensee MDPI, Basel, Switzerland. This article is an open access article distributed under the terms and conditions of the Creative Commons Attribution (CC BY) license (https://creativecommons.org/licenses/by/4.0/).
Share and Cite
Shara, M.; Basyuni, M.; Hasanuddin. Potential of Phylloplane Fungi from Mangrove Plant (Rhizophora apiculata Blume) as Biological Control Agents against Fusarium oxysporum f. sp. cubense in Banana Plant (Musa acuminata L.). Forests 2023, 14, 167. https://doi.org/10.3390/f14020167
Shara M, Basyuni M, Hasanuddin. Potential of Phylloplane Fungi from Mangrove Plant (Rhizophora apiculata Blume) as Biological Control Agents against Fusarium oxysporum f. sp. cubense in Banana Plant (Musa acuminata L.). Forests. 2023; 14(2):167. https://doi.org/10.3390/f14020167
Chicago/Turabian StyleShara, Melya, Mohammad Basyuni, and Hasanuddin. 2023. "Potential of Phylloplane Fungi from Mangrove Plant (Rhizophora apiculata Blume) as Biological Control Agents against Fusarium oxysporum f. sp. cubense in Banana Plant (Musa acuminata L.)" Forests 14, no. 2: 167. https://doi.org/10.3390/f14020167
APA StyleShara, M., Basyuni, M., & Hasanuddin. (2023). Potential of Phylloplane Fungi from Mangrove Plant (Rhizophora apiculata Blume) as Biological Control Agents against Fusarium oxysporum f. sp. cubense in Banana Plant (Musa acuminata L.). Forests, 14(2), 167. https://doi.org/10.3390/f14020167

